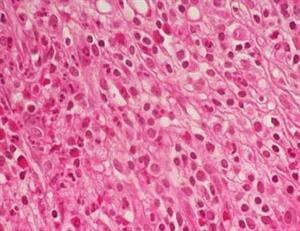
сполучна4.JPG

Клітини тварин, як і рослин, об'єднані у тканини.
Тканини складаються з клітин і міжклітинної речовини. Кожна тканина виконує певну функцію, яка пов'язана з її будовою. Тому тканини відрізняються високою специфічністю.
Тканина — це сукупність клітин і міжклітинної речовини, які мають спільне походження, схожу будову і виконують певну функцію.
Тіло тварин складається з чотирьох основних типів тканин: епітеліальної, м'язової, сполучної і нервової.
Епітеліальна тканина покриває тіло і вистилає його порожнини та внутрішні органи, входить до складу залоз. Різні типи епітеліальної тканини можуть складатися з одного, або декількох щільно прилеглих клітин, між якими практично немає міжклітинної речовини. Епітеліальні тканини виконують захисну, покривну, всмоктувальну, видільну функції.


Епітеліальні тканини
М'язова тканина забезпечує рухові функції організму і складається зі скоротливих клітин або волокон, які з'єднанні між собою за допомогою сполучної тканини. Розрізняють два основні типи м'язової тканини — посмуговану і непосмуговану.

М'язові тканини
Сполучні тканини містять дуже багато міжклітинної речовини (у вигляді волокон, кісткових пластинок, хрящів, рідини). Ці особливості будови дозволяють сполучним тканинам виконувати опорну (кістки, хрящі, сухожилля), захисну (підшкірний жир), живильну (кров, лімфа) функції. Сполучні тканини і мають найвищу здатність до регенерації при пошкодженнях.

Різновиди сполучної тканини
Нервова тканина складається із нейронів, які здатні сприймати подразнення та передавати керівні сигнали від мозку до органів. Завдяки цій тканині відбувається регуляція усіх функцій організму.

Нервова тканина

Нейрон
Джерела:
Біологія: підруч. для 7-го кл. закл. заг. серед. освіти / Балан П.Г., Кулініч О.М., Юрченко Л.П. — Київ: Генеза, 2024. с. 135-139.
Біологія: підруч. для 7-го кл. зал. заг. серед. освіти / Задорожний К., Ягенська Г., Павленко О., Додь В. — Київ: Освіта, 2024. с. 125-129.
Біологія: підруч. для 7-го кл. зал. заг. серед. освіти / Андерсон О.А., Вихренко М.А., Чернінський А.О., Андерсон А.О. — Київ: Школяр, 2024. с. 126-127
Біологія: підруч. для 7-го кл. закл. заг. серед. освіти / Горобець Л.В., Кокар Н.В., Кравець І.В. Жирська Г.Я. — Тернопіль: Астон, 2024. с. 171-174.